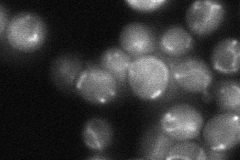

View description
Cysteine desulfurase involved in iron-sulfur cluster (Fe/S) biogenesis; required for the post-transcriptional thio-modification of mitochondrial and cytoplasmic tRNAs; essential protein located predominantly in mitochondria
Localization:
Intensity:
Fold change:
Significance:
-
C’ GFP library in SD

mitochondria98.85 -
N' NOP1pr-GFP in SD

mitochondria151.632 -
N' TEF2pr-mCherry in SD

missing0 -
N' NATIVEpr-GFP in SD
mitochondria39.9972 -
N' TEF2pr-VC and Cyto-VN in SD

#N/A0 -
C’ GFP library in SD+DTT

mitochondria133.411.34No -
C’ GFP library in SD+H2O2

mitochondria79.440.8No -
C’ GFP library in Starvation Media

mitochondria139.321.4Yes -
C’ GFP library on the background of Pup2-DaMP

N/A -
C’ GFP library on the background of CCT mutant

N/A0N/AYes
